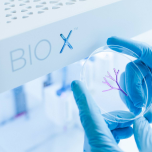
BIO X

BIO X
Products

Information
BIO X is the most user-friendly and flexible bioprinter in the world, providing the user with an unparalleled bioprinting experience. The built-in features along with the new BIO X software managed through the large touchscreen display minimize the learning curve and ensure you will receive the results you want.
Bioprinted tissue can be used in drug discovery where researchers can test new potential treatments and evaluate efficacy in very early stages. New drugs and treatments will potentially reach clinical trials faster with a decreased number of failures and reduced need for animal testing.
BIO X is the next-generation bioprinter, bringing scientists closer to the future of medicine.